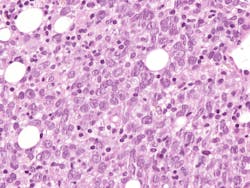
6835c373e35f0b1a53f27731 Dreamstime Xxl 342822543 1 6835c373e35f0b1a53f27731 Dreamstime Xxl 342822543 1

Foresight Diagnostics, Inc. announced the presentation of independent validation data demonstrating the prognostic performance of its Foresight CLARITY MRD assay in patients with newly diagnosed diffuse large B-cell lymphoma (DLBCL).
The results will be shared in an oral presentation at the 2025 American Society of Clinical Oncology (ASCO) Annual Meeting taking place from May 31 to June 3, 2025, in Chicago, Illinois.
Key findings:
- ctDNA-MRD was detected at end of treatment (EOT) in 24% of patients; 76% were MRD-negative.
- MRD-positive patients showed significantly lower progression-free survival (28% vs. 88%) and overall survival (50% vs. 97%) compared to MRD-negative patients.
- Among patients who were MRD-negative and achieved PET complete response at EOT, 2-year progression-free survival (PFS) and overall survival (OS) were 91% and 99%, respectively.
- All patients who failed to achieve complete response by PET and remained MRD-positive experienced relapse.
- ctDNA-MRD remained a powerful independent predictor of outcomes across multiple clinical subgroups, even after adjusting for standard prognostic factors.
For more details about the presentations, visit the Foresight Diagnostics website.
About the Author
Sign up for our eNewsletters
Get the latest news and updates